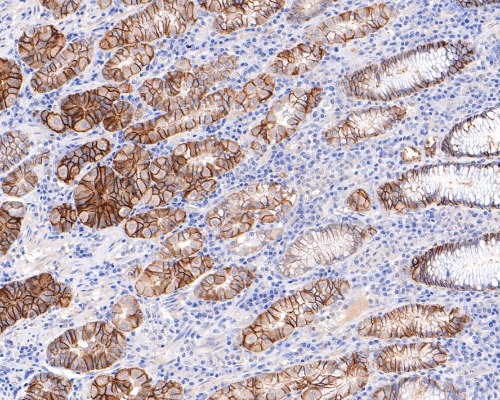
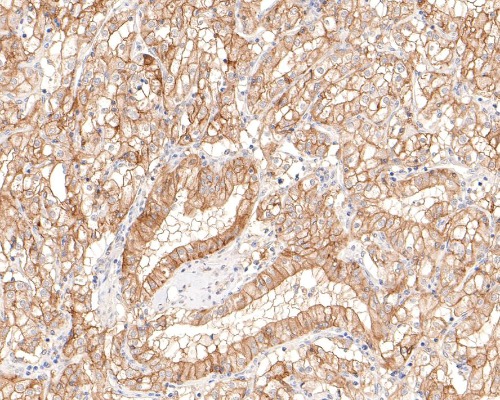

CAIX Rabbit Monoclonal Antibody(ARA899)
CAT.NO. : ARA6734
RMB Please choose
RMB Please choose
Size:
Trail, Bulk size or Custom requests Please contact us
*产品价格可能会有所调整,请以品牌方官网实时更新的价格为准,以确保准确性。
Background
Carbonic anhydrases (CAs) are members of a large family of zinc metalloenzymes that catalyze the reversible hydration of carbon dioxide. CAs are involved in a variety of biological processes including respiration, calcification, acid-base balance and bone resorption, as well as the formation of aqueous humor, cerebrospinal fluid, saliva and gastric juice. They show extensive diversity in distribution and in their subcellular localization. The human CA2 gene, which maps to chromosome 8q21, encodes CA II, a cytoplasmic protein that has the highest turnover rate and widest tissue distribution of any known human CA isozyme. The human CA4 gene, which maps to chromosome 17q23, encodes CA IV, a membrane-anchored isozyme that is expressed on the luminal surfaces of pulmonary capillaries and proximal renal tubules. The human CA9, CA12 and CA14 genes, which map to chromosomes 9p13, 15q22 and 1q21, respectively, encode transmembrane proteins that have unique patterns of tissue-specific expression. CA IX is specifically expressed in clear-cell renal carcinomas, whereas CA XII is highly expressed in normal tissues, such as kidney, colon and pancreas. Human CA XIV is also expressed in normal tissues, such as brain, but differs from CA XII in its expression pattern.
Application
|
Application |
Dilution Ratio |
|
IHC-P |
1:200-1:500 |
Overview
|
Antibody Type |
Recombinant Rabbit monoclonal Antibody |
|
Immunogen |
Recombinant protein within Human Carbonic anhydrase 9 aa 184-276 / 459 |
|
Species Reactivity |
Human |
|
Validated Applications |
WB, IHC-P, IF-Tissue, mIHC |
|
Molecular Weight |
Predicted band size: 50 kDa |
|
Positive Control |
Human lung tissue lysates, human liver tissue, human stomach tissue, human renal clear cell carcinoma tissue |
|
Conjugation |
unconjugated |
|
Form |
Liquid |
|
Concentration |
1μg/μl |
|
Storage Buffer |
1*TBS (pH7.4), 0.05% BSA, 40% Glycerol. Preservative: 0.05% Sodium Azide |
|
Isotype |
IgG |
|
Purification Method |
Protein A affinity purified |
Data

Immunohistochemical staining of human liver tissue using CAIX Rabbit Monoclonal Antibody(ARA899)
Immunohistochemical staining of human stomach tissue using CAIX Rabbit Monoclonal Antibody(ARA899)
Immunohistochemical staining of human renal clear cell carcinoma tissue using CAIX Rabbit Monoclonal Antibody(ARA899)
Storage
Store at 4°C short term. For long term storage, store at -20°C, avoiding freeze/thaw cycles.
Research Use Only
For Research Use Only. Not for use in diagnostic procedures.
New Products
